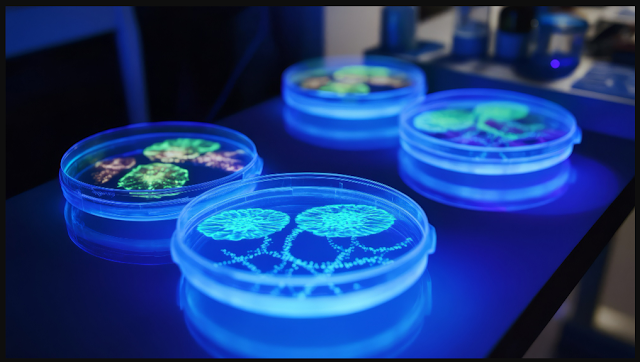

Συνεχίζεται η αγωνία στις ΗΠΑ σε σχέση με τον κίνδυνο ύπαρξης βιολογικής απειλής. Οι αμερικανικές αρχές ανακοίνωσαν τη Δευτέρα ότι συνέλαβαν έναν Κινέζο ερευνητή που κατηγορείται για λαθρεμπόριο βιολογικού υλικού στη χώρα, στην δεύτερη τέτοια περίπτωση μέσα σε λίγες ημέρες – Θυμηθείτε ΕΔΩ την πρώτη.
Το FBI ανέφερε ότι ο ερευνητής, Κινέζος διδακτορικός φοιτητής στο Κολλέγιο Επιστημών και Τεχνολογίας Ζωής στο Πανεπιστήμιο Επιστήμης και Τεχνολογίας Huazhong στην Ουχάν, συνελήφθη την Κυριακή στο αεροδρόμιο του Ντιτρόιτ. Σημειώνεται πως από εργαστήριο στην Ουχάν φέρεται να ξεκίνησε η λεγόμενη πανδημία COVID.
Σύμφωνα με την καταγγελία, από τον Σεπτέμβριο, ο ερευνητής φέρεται να έχει στείλει τέσσερις αποστολές από την Κίνα που περιείχαν κρυμμένο βιολογικό υλικό σε μέλη του προσωπικού ενός εργαστηρίου στο Πανεπιστήμιο του Μίσιγκαν, όπου σχεδίαζε να περάσει ένα χρόνο ολοκληρώνοντας ένα πρότζεκτ. Οι αξιωματούχοι δήλωσαν ότι ο Κινέζος έκανε ψευδείς δηλώσεις σχετικά με τις αποστολές όταν ομοσπονδιακοί πράκτορες τον ανέκριναν σχετικά με αυτές όταν έφτασε στις Ηνωμένες Πολιτείες από τη Σαγκάη.
Δύο Κινέζοι υπήκοοι κατηγορήθηκαν την περασμένη εβδομάδα, αφού το FBI δήλωσε ότι διαπιστώθηκε ότι ο ένας προσπάθησε να εισαγάγει λαθραία έναν τοξικό μύκητα στις Ηνωμένες Πολιτείες, επίσης για έρευνα στο Πανεπιστήμιο του Μίσιγκαν, όπως ισχυρίστηκε.
Σύμφωνα με την νέα καταγγελία, το βιολογικό υλικό για το οποίο κατηγορείται ο ερευνητής ότι λαθρεμπορεύεται —μερικές φορές κρυμμένο ανάμεσα σε σελίδες ενός βιβλίου— σχετίζεται με ασκαρίδες και απαιτεί κυβερνητική άδεια.
Η καταγγελία ισχυρίζεται επίσης ότι ο συλληφθής διέγραψε το περιεχόμενο της ηλεκτρονικής της συσκευής τρεις ημέρες πριν φτάσει στο Ντιτρόιτ.
el.gr